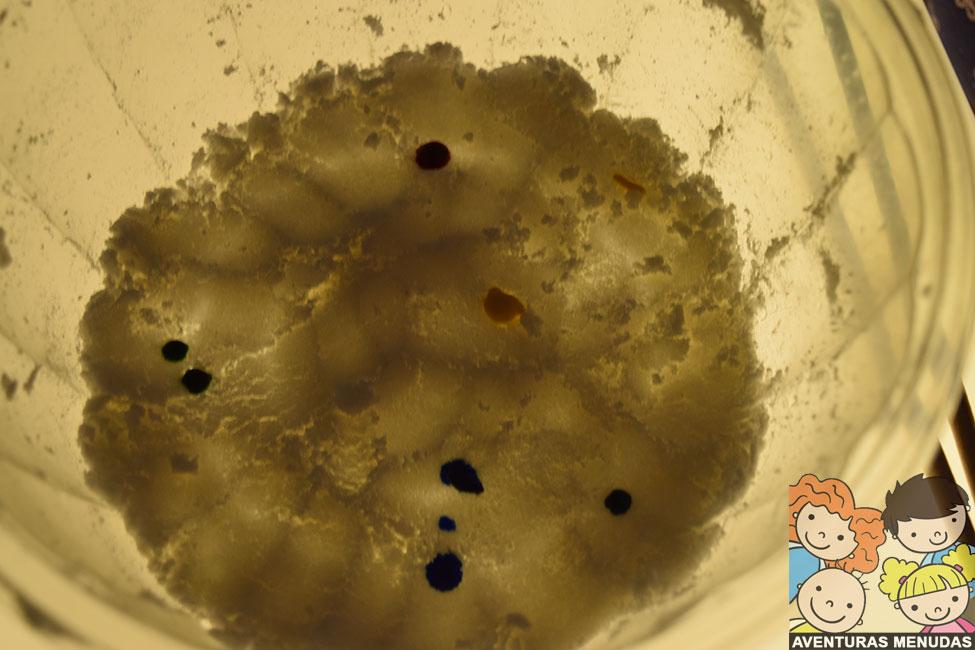

No es la primera vez que hacemos nieve casera, la primera vez quise hacerla para compartirla en el blog, pero todo fue tan rápido que no pude hacer ni una foto. Bueno sí, del cuarto de baño nevado, que parecía que se había roto nuestro tejado y los astros se habían alineado para nevar solo en nuestra casa. Preparé todo para hacer nieve justo antes del baño. Cuando estaban jugando con ella me fui un segundo a buscar la cámara de fotos y cuando volví…. ellos eran muñecos de nieve y el baño las montañas nevadas… jajajajaja. Tuvimos bicarbonato por todas partes durante varios días.
Esta vez preparé todo desde el momento 0 de empezar a hacer el experimento, así podía hacer alguna foto antes de que comenzara a nevar… jajajaja.
Los ingredientes son súper sencillos:
Bicarbonato sódico
Espuma de afeitar
Otros elementos interesantes:
Bandejas
Recipientes
Palitos de helado
Colorantes
Mesa de luz: podéis hacer una muy sencilla en 5 minutos siguiendo este post.
La espuma de afeitar puedes coger la más barata que encuentres en el súper, ya que sale igual con una que con otra.
Las proporciones, pues depende de la cantidad de bicarbonato que uses, la idea es incorporar el bicarbonato en una bandeja e ir añadiendo espuma de afeitar hasta que comience a tener una textura similar a la nieve y que se pueda manipular, hacer bolas y se compacte bien.
Así nosotros usamos poco bicarbonato la verdad, pero el que teníamos por casa… también mejor para que no llegara la nieve a toooooooooooda la casa… jajaja.
Empezaron a jugar y decidí incorporar la MESA DE LUZ a la actividad. Todo un éxito. Aplanaban la nieve, la amontonaban en un lado, hacían bolas, de todo. Cuando experimentaron todo lo que quisieron, guardamos la nieve en un bote cerrado para usarla en otro momento.
Al día siguiente, decidí añadir más elementos a la masa de nieve que ya habíamos hecho. Para ello, incorporamos los colorantes alimentarios en el experimento.
Dividí la nieve en 3 recipientes, uno más grande y dos pequeños. Les di los colorantes líquidos y fueron poniendo gotas en el bol grande y mezclando el colorante con unos palitos. Parecía que estaban pintando.
El colorante no se llegó a mezclar del todo con la nieve y más bien parecía que teníamos una nieve con tropezones de colores. La verdad es que el efecto al mezclar es genial y con la mesa de luz se potencia mucho más.
Luego mezclaron en unos vasitos agua y unas gotas de colorante alimentario. En cada vasito un color.
Rellenaron varias jeringuillas con el agua de color, una para cada color y con ellas fueron poniendo gotas en los recipientes pequeños que tenían también nieve casera. Genial el efecto de color y esta vez sí mezclándose con la masa de nieve y además, con la mesa de luz, chulísimo.
Iban poniendo gotas de cada color conforme querían, que parecían dibujar en la nieve.
Terminaron de gastar el agua con color de las jeringuillas sobre el recipiente grande, que ya tenía colores incorporados, pero no disueltos.
Después con una cuchara, pasaron las mezclas de cada recipiente pequeño al grande y lo mezclaron todo… La masa resultante es INDESCRIPTIBLE,… jajajaja
Eso sí, como tienen muchas ganas de experimentar y tocar con las manos, no dudaron en meterlas en el recipiente y tocar y amasar y dejar caer la masa resultante.
Experimentación pura y dura.
Así que si queréis una o dos tardes divertidas de experimentación, solo con bicarbonato, espuma de afeitar y unas bandejas, tenéis una actividad super sencilla de hacer y donde disfrutan mucho. Si además incorporáis el colorante, pues mejor que mejor.
Eso sí, luego la zona queda un poco llena de nieve, bicarbonato y otros tipos de restos. Pero bueno, con un poco de ayuda de todos, la cosa se arregla en un periquete.
Si os gusta experimentar, no dudéis en probar también los experimentos con hielo, agua y sal o los experimentos para conseguir Nubes con lluvia de colores.
SI OS HA GUSTADO EL POST, NO DUDÉIS EN DAR A ME GUSTA, COMENTAR VUESTRAS IMPRESIONES Y COMPARTIR
Archivado en: Sin categoría